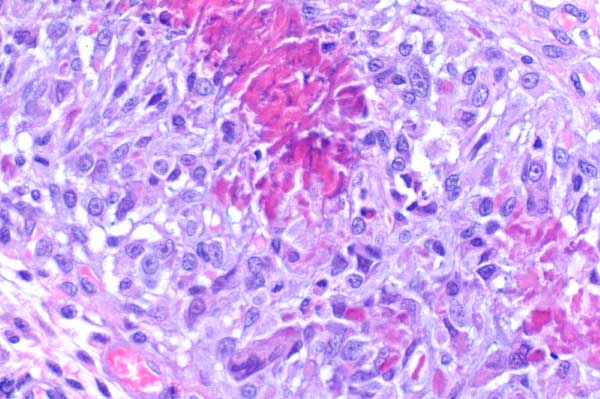

| 40x | Hematoxylin and Eosin | ||||
| Close Window | Macro View | Show Help | Back | |
|
These foci are surrounded by abundant macrophages (sometimes forming multinucleated giant cells (arrow)), eosinophils, neutrophils, lymphocytes and mast cells.
|
||||

|
||||
| Return | ||||
|
These foci are surrounded by abundant macrophages (sometimes forming multinucleated giant cells (arrow)), eosinophils, neutrophils, lymphocytes and mast cells.
|
||||